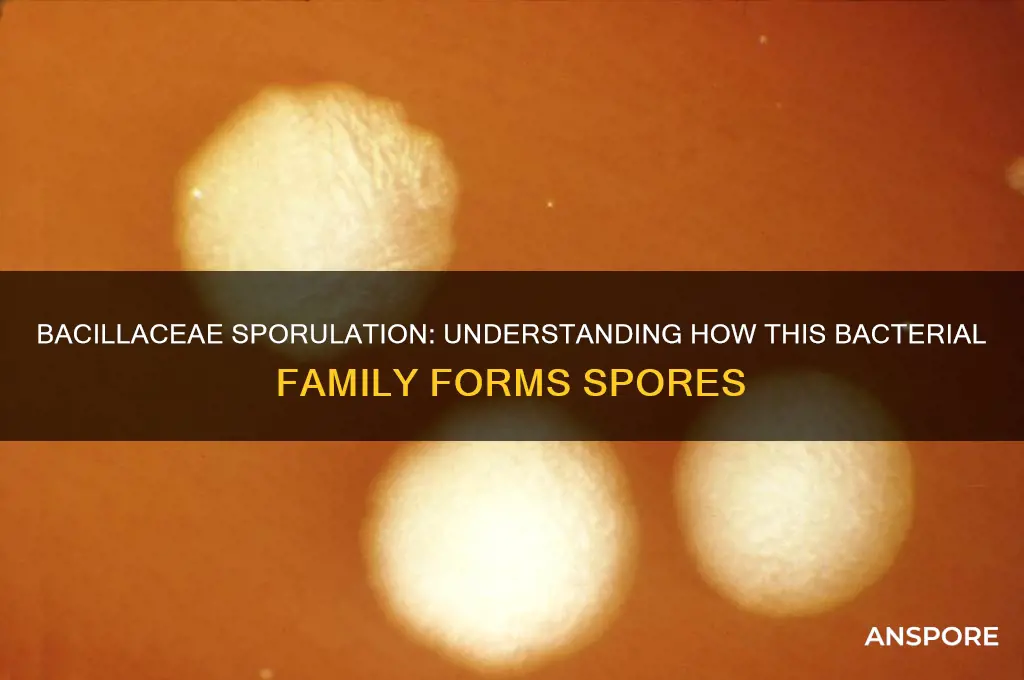
does bacillaceae form spores

Bacillaceae, a family of Gram-positive bacteria, is well-known for its remarkable ability to form highly resistant endospores under adverse environmental conditions. These spores serve as a survival mechanism, allowing the bacteria to endure extreme temperatures, desiccation, and other harsh conditions that would otherwise be lethal. Among the most prominent members of Bacillaceae is the genus *Bacillus*, which includes species like *Bacillus subtilis* and *Bacillus anthracis*, both of which are renowned for their spore-forming capabilities. The process of sporulation involves a complex series of morphological and biochemical changes, resulting in the formation of a durable spore that can remain dormant for extended periods until favorable conditions return. Understanding whether and how Bacillaceae forms spores is crucial for various fields, including microbiology, biotechnology, and medicine, as these spores have significant implications for food preservation, bioremediation, and pathogen control.
| Characteristics | Values |
|---|---|
| Spore Formation | Yes, Bacillaceae is known for its ability to form highly resistant endospores. |
| Spore Location | Endospores are formed within the bacterial cell, often centrally or terminally. |
| Spore Resistance | Highly resistant to heat, radiation, desiccation, and chemicals. |
| Spore Function | Serve as a survival mechanism during unfavorable environmental conditions. |
| Spore Germination | Spores can germinate and return to vegetative growth when conditions improve. |
| Spore Morphology | Spores are typically oval or cylindrical, with a thick, multilayered coat. |
| Spore Staining | Spores often stain differently from vegetative cells, appearing as refractile bodies under a microscope. |
| Spore-Forming Genera | Includes genera like Bacillus, Clostridium, and Paenibacillus. |
| Environmental Role | Spores play a key role in the survival and dispersal of Bacillaceae in diverse environments. |
| Industrial Applications | Spores are used in biotechnology, probiotics, and as indicators of sterilization processes. |
Explore related products
What You'll Learn
- Sporulation Process: How Bacillaceae initiates and completes spore formation under stress conditions
- Spore Structure: Key components and layers of Bacillaceae spores for survival
- Environmental Triggers: Factors like nutrient depletion or pH changes inducing sporulation
- Spore Germination: Conditions and mechanisms for Bacillaceae spores to return to vegetative state
- Survival Advantages: How spore formation aids Bacillaceae in enduring harsh environments

Sporulation Process: How Bacillaceae initiates and completes spore formation under stress conditions
Bacillaceae, a family of Gram-positive bacteria, is renowned for its ability to form highly resistant endospores, a survival mechanism triggered by adverse environmental conditions. This process, known as sporulation, is a complex, multi-stage transformation that ensures the bacterium’s long-term survival in the face of stressors like nutrient depletion, desiccation, or extreme temperatures. Understanding how Bacillaceae initiates and completes spore formation under stress is critical for fields ranging from microbiology to biotechnology, as these spores can withstand conditions lethal to vegetative cells.
The sporulation process begins with the activation of a genetic program triggered by stress signals, such as the depletion of carbon or nitrogen sources. In *Bacillus subtilis*, a model organism for sporulation studies, this involves the activation of the master regulator Spo0A, which responds to stress by phosphorylating and initiating the expression of genes required for spore formation. This early stage is marked by an asymmetric cell division, where the cell divides into a larger mother cell and a smaller forespore. The mother cell then engulfs the forespore, creating a double-membrane structure that serves as the foundation for the developing spore.
As sporulation progresses, the forespore undergoes a series of morphological and biochemical changes. The cortex, a thick layer of peptidoglycan, is synthesized between the two membranes, providing structural integrity. Concurrently, the spore coat, composed of multiple layers of proteins, is assembled around the cortex, offering additional protection against environmental insults. Inside the forespore, DNA is compacted and protected by small acid-soluble proteins (SASPs), which shield it from damage caused by heat, radiation, or chemicals. This stage is critical, as the spore’s resistance properties are directly tied to the integrity of these protective layers.
The final stages of sporulation involve the completion of the spore’s protective structures and the lysis of the mother cell, releasing the mature spore into the environment. The spore is now metabolically dormant and can survive for years, even centuries, in harsh conditions. Reactivation, or germination, occurs when environmental conditions improve, such as the presence of nutrients and appropriate temperature. This process is tightly regulated to ensure that the spore only returns to vegetative growth when survival is likely.
Practical applications of Bacillaceae sporulation are vast. In biotechnology, spores are used as robust delivery vehicles for enzymes or vaccines, leveraging their stability. In agriculture, spore-forming bacteria like *Bacillus thuringiensis* are employed as bioinsecticides. However, their resilience also poses challenges, such as their role in food spoilage or their ability to survive sterilization processes. Understanding the sporulation process allows scientists to manipulate these bacteria for beneficial purposes while mitigating risks. For instance, controlling sporulation in food production environments can reduce contamination, while engineering spores for targeted drug delivery holds promise in medicine.
In summary, the sporulation process of Bacillaceae is a remarkable adaptation to stress, involving a series of coordinated genetic, morphological, and biochemical changes. From the initial activation of Spo0A to the release of a mature spore, each step is finely tuned to ensure survival. This knowledge not only deepens our understanding of bacterial resilience but also opens avenues for practical applications across industries. Whether harnessing spores for biotechnology or combating them in food safety, the sporulation process remains a focal point of scientific inquiry and innovation.
Mildew Spores in Your Home: Uncovering the Link to Hair Loss
You may want to see also

Spore Structure: Key components and layers of Bacillaceae spores for survival
Bacillaceae, a family of Gram-positive bacteria, is renowned for its ability to form highly resilient spores. These spores are not merely dormant cells but intricate structures engineered for survival in harsh conditions. Understanding their architecture reveals the secrets behind their durability.
At the core of a Bacillaceae spore lies the core wall, a modified peptidoglycan layer that provides structural integrity. This is surrounded by the spore cortex, a thick layer of specialized peptidoglycan containing high levels of calcium dipicolinate, which protects against heat and desiccation. The inner membrane encloses the core, while the outer membrane acts as a selective barrier. Crucially, the spore coat, composed of multiple protein layers, offers additional protection against enzymes, chemicals, and physical stress. Each layer serves a distinct purpose, collectively enabling the spore to withstand extreme environments, from UV radiation to nutrient deprivation.
Consider the spore coat as the unsung hero of Bacillaceae survival. Its keratin-like proteins form a tough, impermeable shield, akin to a suit of armor. This layer is not static; it can adapt to environmental cues, such as pH changes or temperature shifts, by altering its protein composition. For instance, in alkaline conditions, certain coat proteins become more rigid, enhancing resistance. Practical applications of this knowledge include using spore coat proteins in biotechnology to stabilize enzymes or vaccines. Understanding these adaptive mechanisms could also inform strategies for controlling pathogenic Bacillaceae species, such as *Bacillus anthracis*.
To visualize the spore’s complexity, imagine a Russian nesting doll, where each layer adds a new level of protection. The exosporium, the outermost layer, is often likened to the final wrapper, though not all Bacillaceae spores possess it. This layer can bind to surfaces, aiding in spore dispersal and attachment to hosts or environments. Beneath it, the spore coat’s multiple layers act as a multi-tiered defense system, each with unique proteins tailored to resist specific threats. For example, some coat proteins inhibit proteases, while others repel hydrophobic compounds. This modular design allows spores to survive for decades, even centuries, in soil, water, or extreme conditions like outer space.
From a survival standpoint, the spore’s structure is a masterclass in efficiency. The germination cortex, rich in calcium, acts as a reservoir that, when released, triggers rehydration and metabolic reactivation. This process is tightly regulated, ensuring spores only germinate when conditions are favorable. For researchers and industries, this mechanism offers insights into preserving biological materials. For instance, freeze-drying techniques mimic spore desiccation to stabilize vaccines or probiotics. Conversely, understanding germination inhibitors could lead to new antimicrobial strategies against spore-forming pathogens.
In summary, Bacillaceae spores are not just survivalists; they are survival architects. Each layer—from the core wall to the exosporium—is a deliberate design choice, optimized for resilience. By studying these structures, we unlock principles of biomimicry, from preserving pharmaceuticals to combating infections. Whether in a lab or the wild, the spore’s architecture remains a testament to nature’s ingenuity in overcoming adversity.
Do Spore Mines Require Charging? Understanding Their Mechanics and Functionality
You may want to see also

Environmental Triggers: Factors like nutrient depletion or pH changes inducing sporulation
Bacillus species, renowned for their resilience, employ sporulation as a survival strategy in response to environmental stressors. Among these triggers, nutrient depletion stands out as a critical factor. When essential resources like carbon, nitrogen, or phosphorus become scarce, Bacillus cells initiate a complex genetic program leading to spore formation. This process, known as endospore formation, involves the encapsulation of the bacterial genome within a protective layer, ensuring survival in harsh conditions. For instance, in laboratory settings, researchers often induce sporulation by transferring Bacillus cultures to nutrient-depleted media, such as minimal salts medium, where cells rapidly shift from vegetative growth to spore development within 8–12 hours.
PH changes also play a pivotal role in triggering sporulation in Bacillaceae. These bacteria are particularly sensitive to shifts in environmental pH, with both acidic and alkaline conditions acting as potent inducers. Studies have shown that a drop in pH to levels below 5.5 or an increase above 9.0 can prompt Bacillus subtilis, a model organism in this family, to enter the sporulation pathway. This response is thought to be mediated by stress-responsive sigma factors, which activate genes involved in spore formation. Practical applications of this knowledge include the use of pH-adjusted solutions in food preservation, where controlled acidification can inhibit vegetative growth while promoting spore formation, thereby extending shelf life.
Understanding the interplay between environmental triggers and sporulation has significant implications for biotechnology and industry. For example, in the production of probiotics or enzymes, controlling nutrient availability and pH can optimize spore yield, enhancing product stability. In wastewater treatment, Bacillus spores are employed for their ability to degrade organic matter under nutrient-limited conditions, a process facilitated by their sporulation response. However, this very resilience poses challenges in clinical settings, where Bacillus spores can survive disinfection protocols, necessitating the use of sporicides like hydrogen peroxide (at concentrations of 6–10%) or heat treatment (121°C for 15–30 minutes) to ensure eradication.
Comparatively, while nutrient depletion and pH changes are potent triggers, other factors like temperature shifts and oxygen limitation also influence sporulation, albeit to varying degrees. For instance, temperature stress (e.g., 40–45°C) can accelerate sporulation in some Bacillus species, but its effectiveness pales in comparison to nutrient deprivation. This highlights the hierarchical nature of environmental triggers, where nutrient depletion often takes precedence in inducing sporulation. Such insights underscore the importance of tailoring environmental conditions to either promote or inhibit sporulation, depending on the desired outcome, whether in industrial applications or infection control.
In conclusion, the ability of Bacillaceae to form spores in response to environmental triggers like nutrient depletion and pH changes is a testament to their evolutionary adaptability. By manipulating these factors, researchers and practitioners can harness the benefits of sporulation while mitigating its drawbacks. For instance, in agriculture, nutrient-limited formulations can enhance spore-based biofertilizers, improving crop resilience. Conversely, in healthcare, understanding these triggers aids in developing more effective sterilization methods. This nuanced control over sporulation not only advances scientific knowledge but also translates into practical solutions across diverse fields.
Can Dryers Effectively Eliminate Mold Spores from Your Clothes?
You may want to see also
Explore related products

Spore Germination: Conditions and mechanisms for Bacillaceae spores to return to vegetative state
Bacillaceae, a family of Gram-positive bacteria, are renowned for their ability to form highly resistant endospores. These spores serve as a survival mechanism, allowing the bacteria to endure harsh environmental conditions such as extreme temperatures, desiccation, and chemical exposure. However, the true marvel lies not in spore formation but in spore germination—the process by which these dormant spores revert to their vegetative, metabolically active state. Understanding the conditions and mechanisms that trigger this transformation is crucial for applications in biotechnology, medicine, and environmental science.
Spore germination in Bacillaceae is a tightly regulated, multi-step process that begins with the perception of specific environmental cues. Key triggers include nutrients like amino acids (e.g., L-valine, L-alanine, and L-asparagine), purine nucleosides (e.g., inosine and guanosine), and changes in pH or temperature. For instance, *Bacillus subtilis* spores require a minimum concentration of 1–5 mM L-valine to initiate germination. These signals are detected by germinant receptors (GRs) embedded in the spore’s inner membrane. Upon activation, GRs trigger the release of dipicolinic acid (DPA), a calcium-chelating molecule that stabilizes the spore’s core, and the breakdown of peptidoglycan cortex layers surrounding the spore. This cascade of events rehydrates the spore and restores metabolic activity, marking the transition to the vegetative state.
While the process appears straightforward, spore germination is fraught with challenges. Incomplete or aborted germination can occur if environmental conditions are suboptimal or if the spore is damaged. For example, low nutrient concentrations or the absence of specific germinants can stall the process. Researchers have exploited this sensitivity to develop strategies for controlling spore activation, such as using germinant cocktails to synchronize germination in biotechnological applications. Conversely, inhibiting germination is a target in food safety and medical contexts, where Bacillaceae spores (e.g., *Bacillus cereus* and *Clostridium botulinum*) pose risks as contaminants.
Practical applications of spore germination knowledge are diverse. In agriculture, controlled germination of *Bacillus thuringiensis* spores enhances their efficacy as bioinsecticides. In medicine, understanding germination mechanisms aids in developing antimicrobial strategies against spore-forming pathogens. For instance, targeting GRs or the cortex-lytic enzymes could prevent spore activation in infections. Additionally, in the food industry, modulating germination conditions helps in sterilizing canned goods or fermenting products like natto, where *Bacillus subtilis* spores are intentionally activated.
In conclusion, spore germination in Bacillaceae is a finely tuned process driven by specific environmental cues and molecular mechanisms. By manipulating these conditions, scientists can harness the potential of spores in beneficial applications while mitigating their risks. Whether optimizing biotechnological processes or combating pathogens, a deep understanding of germination dynamics is indispensable for leveraging the unique capabilities of Bacillaceae spores.
Are Fern Spores Dangerous? Uncovering the Truth About These Tiny Particles
You may want to see also

Survival Advantages: How spore formation aids Bacillaceae in enduring harsh environments
Bacillaceae, a family of Gram-positive bacteria, are renowned for their ability to form highly resistant endospores, a trait that significantly enhances their survival in extreme conditions. These spores are not just a passive defense mechanism but a sophisticated adaptation that allows Bacillaceae to endure environments that would be lethal to most other life forms. The process of spore formation, or sporulation, is a complex, energy-intensive transformation that results in a dormant, resilient cell capable of withstanding desiccation, radiation, and extreme temperatures.
Consider the analytical perspective: spore formation in Bacillaceae is a strategic response to nutrient depletion and environmental stress. When resources become scarce, the bacterium initiates a series of genetic and morphological changes. The cell divides asymmetrically, producing a smaller forespore within the larger mother cell. The forespore then undergoes multiple layers of protective coating, including a thick peptidoglycan cortex and a proteinaceous coat, which together create a barrier against external threats. This multi-layered defense system is akin to a biological bunker, safeguarding the genetic material and essential enzymes within.
From an instructive standpoint, understanding spore formation can guide practical applications in biotechnology and medicine. For instance, spores of *Bacillus subtilis* are used as probiotics in animal feed to improve gut health, leveraging their ability to survive the digestive tract. In industrial settings, spores are employed in bioremediation to clean up toxic waste, as they can remain viable until conditions improve. To maximize their utility, spores should be stored in a cool, dry environment, as moisture can trigger germination prematurely. For laboratory cultures, a spore suspension can be prepared by heat-shocking cells at 80°C for 10 minutes, ensuring only spores survive.
A comparative analysis highlights the superiority of Bacillaceae spores over other bacterial survival strategies. Unlike cysts formed by some protozoa, which are less resistant to heat and chemicals, Bacillaceae spores can withstand autoclaving at 121°C for 15 minutes. Compared to vegetative bacterial cells, which succumb quickly to UV radiation, spores can absorb up to 10,000 times more radiation without losing viability. This unparalleled resilience makes Bacillaceae spores ideal candidates for long-term survival in extraterrestrial environments, as evidenced by their inclusion in experiments testing the limits of life in space.
Descriptively, the spore’s structure is a marvel of evolutionary engineering. The innermost layer, the core, contains the bacterial genome and is dehydrated to a near-crystalline state, minimizing chemical reactions that could damage DNA. Surrounding this is the germ cell wall, which provides additional protection. The outer coat, often studded with proteins and carbohydrates, acts as a selective barrier, preventing harmful substances from entering while allowing essential nutrients to pass during germination. This intricate design ensures that the spore remains metabolically inactive yet poised to revive when conditions become favorable.
In conclusion, spore formation in Bacillaceae is a survival masterclass, combining genetic precision, structural ingenuity, and environmental adaptability. Whether in the scorching deserts of Earth or the vacuum of space, these spores exemplify life’s tenacity. By studying their mechanisms, we not only gain insights into microbial survival but also unlock potential applications in fields ranging from healthcare to astrobiology. The next time you encounter a harsh environment, remember: Bacillaceae spores are likely there, waiting patiently for their moment to thrive.
Exploring Spore's Multiplayer: Can You Play Co-op in the Game?
You may want to see also
Frequently asked questions
Yes, Bacillaceae, a family of Gram-positive bacteria, is known for its ability to form highly resistant endospores under adverse environmental conditions.
Spore formation in Bacillaceae is typically triggered by nutrient depletion, especially the lack of carbon and nitrogen sources, as well as other environmental stressors like desiccation or extreme temperatures.
While most members of Bacillaceae are spore-forming, not all genera within the family produce spores. For example, *Paenibacillus* and *Bacillus* are well-known spore-formers, but other genera may not exhibit this characteristic.































